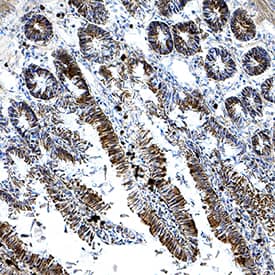
HSPA8/HSC71 antibody in Rat Intestine by Immunohistochemistry (IHC-Fr).

Human/Mouse/Rat HSPA8/HSC71 Antibody
R&D Systems, part of Bio-Techne | Catalog # AF4148


Key Product Details
Species Reactivity
Validated:
Cited:
Applications
Validated:
Cited:
Label
Antibody Source
Product Specifications
Immunogen
Asp534-Gly615
Accession # P11142
Specificity
Clonality
Host
Isotype
Scientific Data Images for Human/Mouse/Rat HSPA8/HSC71 Antibody
Detection of Human/Mouse/Rat HSPA8/HSC71 by Western Blot.
Western blot shows lysates of HeLa human cervical epithelial carcinoma cell line, NIH-3T3 mouse embryonic fibroblast cell line, and L6 rat myoblast cell line. PVDF membrane was probed with 1 µg/mL of Goat Anti-Human/Mouse/Rat HSPA8/HSC71 Antigen Affinity-purified Polyclonal Antibody (Catalog # AF4148) followed by HRP-conjugated Anti-Goat IgG Secondary Antibody (Catalog # HAF017). A specific band was detected for HSPA8/HSC71 at approximately 71 kDa (as indicated). This experiment was conducted using Immunoblot Buffer Group 2.HSPA8/HSC71 in Mouse Intestine.
HSPA8/HSC71 was detected in immersion fixed frozen sections of mouse intestine using Goat Anti-Human/Mouse/Rat HSPA8/HSC71 Antigen Affinity-purified Polyclonal Antibody (Catalog # AF4148) at 3 µg/mL for 1 hour at room temperature followed by incubation with the Anti-Goat IgG VisUCyte™ HRP Polymer Antibody (Catalog # VC004). Tissue was stained using DAB (brown) and counterstained with hematoxylin (blue). Specific staining was localized to epithelial cells in intestinal glands. View our protocol for IHC Staining with VisUCyte HRP Polymer Detection Reagents.HSPA8/HSC71 in Rat Intestine.
HSPA8/HSC71 was detected in immersion fixed frozen sections of rat intestine using Goat Anti-Human/Mouse/Rat HSPA8/HSC71 Antigen Affinity-purified Polyclonal Antibody (Catalog # AF4148) at 3 µg/mL for 1 hour at room temperature followed by incubation with the Anti-Goat IgG VisUCyte™ HRP Polymer Antibody (Catalog # VC004). Tissue was stained using DAB (brown) and counterstained with hematoxylin (blue). Specific staining was localized to epithelial cells in intestinal glands. View our protocol for IHC Staining with VisUCyte HRP Polymer Detection Reagents.Applications for Human/Mouse/Rat HSPA8/HSC71 Antibody
Immunohistochemistry
Sample: Immersion fixed frozen sections of mouse intestine, immersion fixed frozen sections of rat intestine, and immersion fixed paraffin-embedded sections of human kidney
Western Blot
Sample: HeLa human cervical epithelial carcinoma cell line, NIH-3T3 mouse embryonic fibroblast cell line, and L6 rat myoblast cell line
Reviewed Applications
Read 3 reviews rated 4 using AF4148 in the following applications:
Formulation, Preparation, and Storage
Purification
Reconstitution
Formulation
Shipping
Stability & Storage
- 12 months from date of receipt, -20 to -70 °C as supplied.
- 1 month, 2 to 8 °C under sterile conditions after reconstitution.
- 6 months, -20 to -70 °C under sterile conditions after reconstitution.
Background: HSPA8/HSC71
The 70 kDa heat shock proteins (HSP70s) are a highly conserved family of stress response proteins. The HSP70 family of proteins contains both heat/stress inducible and constitutively expressed members known as heat shock cognate proteins. Heat Shock 70 kDa Protein 8 (HSPA8), also known as Heat Shock Cognate Protein 71 (HSC71), HSC70, HSP73, HSPA10 and LPS-associated protein 1 (LAP1), is a 646 amino acid (aa) heat shock cognate protein. Many HSPs function as molecular chaperones, facilitating the folding of other cellular proteins. HSPA8 plays an important role in cells by transiently associating with nascent polypeptides to facilitate correct folding. HSPA8 is a ubiquitously expressed protein and rapidly translocates from the cytoplasm to the nucleus in response to heat shock. Two alternatively spliced variants have been identified. This antibody detects isoform 1 but not isoform 2 (HSC54). Human HSPA8 shares greater than 99% identity with mouse and rat HSPA8.
Long Name
Alternate Names
Entrez Gene IDs
Gene Symbol
UniProt
Additional HSPA8/HSC71 Products
Product Documents for Human/Mouse/Rat HSPA8/HSC71 Antibody
Product Specific Notices for Human/Mouse/Rat HSPA8/HSC71 Antibody
For research use only